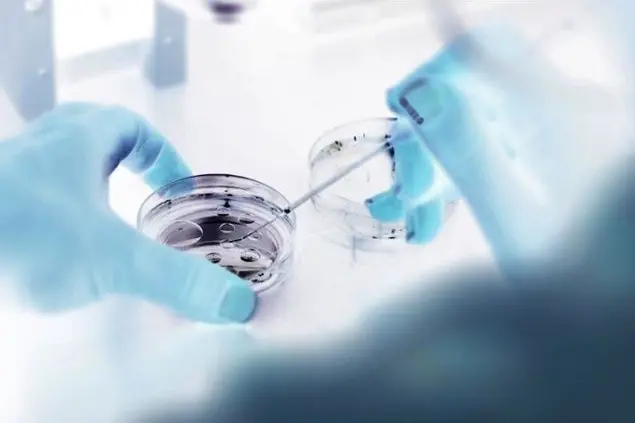

PHOTO
Tutto ciò che è tecnicamente fattibile, è in sé eticamente lecito? Questa domanda ha caratterizzato la nascita della Bioetica negli USA ed è collegata al “grido di allarme” lanciato da Von Ransaellaer Potter di fronte ad un progresso tecno-scientifico privo di guida e separato dalla sfera dei valori umani. La stessa domanda si ripresenta di fronte alla notizia - data nel corso di un congresso dell’American Association for the Advancement of Science, a Austin in Texas - secondo cui un gruppo di ricercatori statunitensi avrebbe dato vita a una entità ibrida pecora-uomo distrutta dopo 28 giorni (limite temporale massimo per cui l’esperimento era stato autorizzato).
L’ibrido è stato ottenuto introducendo cellule staminali adulte riprogrammate nell’embrione di pecora. L’obiettivo perseguito con la “costruzione” dei cosiddetti embrioni “chimera” (embrioni contenenti cellule e informazioni genetiche da specie diverse) sarebbe quello di ottenere organi da trapiantare negli esseri umani. In questo modo, si afferma, si riducono il rischio di “rigetto” (reazione del sistema immunitario che si attiva per distruggere il nuovo organo un corpo estraneo) e la possibile infezione con virus animali. Circa un anno fa gli stessi ricercatori avevano realizzato un ibrido suino-uomo. La novità dell’ultimo esperimento è che una cellula su 10 mila è umana, mentre in quello precedente le cellule umane erano una su 100 mila.
Gli esperti affermano che affinché un trapianto del genere sia efficace, la percentuale di cellule umane in una chimera deve essere almeno dell’uno per cento, quindi il traguardo non è né facile, né immediato. Insomma, non ci sono giustificazioni a questo tipo di sperimentazione basate su evidenze scientifiche. Ma anche qualora questi aspetti fossero tecnicamente superabili (cosa – si afferma – assai dubbia), resta la necessità di una approfondita riflessione sul piano etico e antropologico, perché il fine non giustifica i mezzi. A questo riguardo non si può trascurare il fatto che gli organismi misti uomo-animale sono vietati dalla legge 40 sulla “procreazione medicalmente assistita” (art. 13, comma 3 lettera d) e condannati da un parere del Comitato nazionale per la bioetica del 2009. Non solo, ma nel 2016 il NIH (National Institutes of Health) sigla che indica i principali istituti di ricerca degli USA avevano raccomandato una moratoria su questi tipi di chimerismo adottando, giustamente, il principio di precauzione: data la posta in gioco, nel dubbio sugli esiti di tali sperimentazioni la cautela suggerisce di soprassedere. Non è banale l’abbattimento della barriera tra regno umano e regno animale, se si tratta addirittura di manipolare così a fondo l’umano, generando nuove entità miscelate. Non vanno temuti il progresso, l’evoluzione, la novità sul piano scientifico, ma occorre una stella polare che guidi la ricerca.
L’uguale dignità umana indica non solo che l’essere umano dal concepimento debba essere sempre considerato un fine, un soggetto, una persona (non può essere ridotto a cosa usabile che addirittura può essere distrutta), ma anche che l’identità umana sia onorata e rispettata (non snaturata, manipolata e alterata). Non tutto il fattibile tecnico è perciò in se stesso eticamente lecito e non sempre (come la storia ha dimostrato) il progresso tecno-scientifico coincide con il progresso umano. Inoltre, come giustamente ricorda Antonio G. Spagnolo, Direttore dell’Istituto di Bioetica e Medical Humanities dell’U.C.S.C., il magistero della Chiesa Cattolica considera questi tentativi di ibridazione «un’offesa alla dignità dell’essere umano, a causa della mescolanza di elementi genetici umani ed animali capaci di turbare l’identità specifica dell’uomo» (paragrafo 33 del documento “Dignitas personae”).